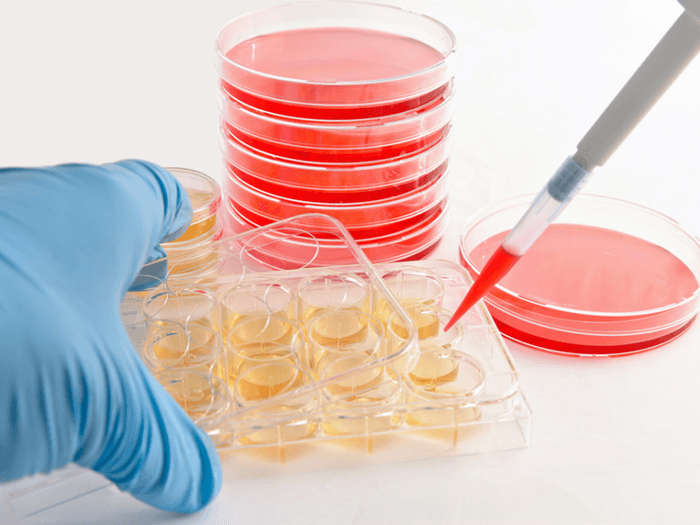

細胞培養タンパク質表面コーティング市場ータンパク質源別、タイプ別、用途別、エンドユーザー別、および地域別ー世界の需要と供給の分析と機会の見通し 2023ー2033年
世界の細胞培養タンパク質表面コーティング市場は、2023年に624.8百万米ドルの市場価値から2033年末までに2265.70百万米ドルに達すると予測されます。また、市場は2023-2033年の予測期間中に13.82%のCAGRで拡大すると予測されます。
リサーチネスターの一部門であるケネスリサーチはこのほど、「細胞培養タンパク質表面コーティング市場」と題する調査報告書を発表した。2033年の世界需要分析と機会展望」(2022年10月04日)を発表しました。詳細な市場産業需要分析と市場成長に影響を与える様々な要因を提供しています。2023-2033年の予測期間、市場価値、市場量、成長率、セグメント、市場プレイヤー、成長促進要因など、市場成長を提供します。調査方法には、市場評価と予測データの算出に基づく過去と現在のデータの収集が含まれます。本レポートのデータ収集には、一次調査と二次調査の両方が含まれます。
レポートのサンプルURL: https://www.kennethresearch.com/sample-request-10352420
市場の成長は、主に幹細胞移植と遺伝子治療における技術的ブレークスルーの影響を受けています。たとえば、ハーバード大学は、Vertex Pharmaceuticals の Melton Lab の研究を利用して、VX-880 を開発しました。これは、1型糖尿病患者を治療するための、幹細胞に由来する完全に形成された膵島細胞療法です。
植物ベースのタンパク質の需要の高まりは、細胞培養タンパク質表面コーティング市場を牽引することです。植物性タンパク質の生産は、2050 年までに約 90 億人の需要を満たすと予想されています。さらに、植物由来タンパク質への投資の増加も市場を後押しすると予想されます。幹細胞研究における人々の好奇心の高まりは、世界の細胞培養タンパク質表面コーティング市場の成長を促進する可能性があります。
市場の成長を促進する主な要因は以下のとおりです。
• 細胞培養タンパク質の研究分野への関心の高まり
• 遺伝的死亡率の上昇
• 神経疾患に苦しむ人々の増加
• 幹細胞形質転換のエスカレーション
• 代替タンパク質への投資の流入
レポートは、市場のさまざまな主要企業の企業プロファイリングで構成されています。会社概要、会社の財務、合併、買収、最近の動向、各会社のリスク分析含まれています。細胞培養タンパク質表面コーティング市場における業界のリーダーはFujifilm Wako Pure Chemical Corporation、Sumitomo Bakelite Co., Ltd、denovoMATRIX GmbH、ScienCell Research Laboratories, Inc.、BioLamina AB、Abcam Plc.、PerkinElmer Inc.、Thermo Fisher Scientific、Merck KgaA、Greiner Bio-One International GmbH、Corning Incorporated、Becton、Dickinson and Companyなどです。
レポートの主なハイライト
• 市場調査は、SWOT分析、バリューチェーン分析、PESTEL分析などのさまざまなツールに基づいて、市場の詳細な分析が提供されます。
• レポートでは、多くの業種の最近の傾向と動向について説明しています。
• 統計の視覚的表現として、いくつかの表、チャート、グラフが含まれています。
• レポートに記載されているビジネス戦略により、投資家や組織は情報に基づいた意思決定を行うことができます。
市場セグメンテーション
細胞培養タンパク質表面コーティング市場は、タンパク質源別(動物由来タンパク質、ヒト由来タンパク質、合成タンパク質、植物由来タンパク質)、タイプ別(セルフコーティング、プレコーティング)、用途別(科学研究、工業生産)、エンドユーザー別(バイオテクノロジー企業、製薬会社、その他)、および地域別などによって分割されています。市場の過去と現在の統計は、各セグメントとそのサブセグメントを分析するために使用されます。各セグメントの市場シェアと成長がさらに評価されます。
世界の細胞培養タンパク質表面コーティング市場は、タンパク質源別に動物由来タンパク質、ヒト由来タンパク質、合成タンパク質、植物由来タンパク質に分割されて、需要と供給が分析されています。これら4つのうち、合成タンパク質セグメントは、2031年末までに最大の市場規模を保持すると予想されています。予測期間中に 13.74% の CAGR で成長すると予想されます。このセグメントは、2021 年に 206.5 百万米ドルの収益を上げました。この成長は、合成タンパク質のより高速な生産のための技術開発によるものです。たとえば、2020 年 5 月、MIT の科学者は、タンパク質の合成を加速する自動卓上機械を発明しました。彼らは、各合成反応で約 99% の効率を達成することに成功、および164 アミノ酸を含むタンパク質を合成することができました。さらに、パーソナライズされたタンパク質の必要性の高まりは、合成タンパク質の需要を促進、およびセグメントの成長に貢献することです。このセグメントは、2031 年末までに 744.8百万米ドルと評価されることも予想されています。
細胞培養タンパク質表面コーティング市場に関するレポートは、地理に基づいて、北米、アジア太平洋、ラテンアメリカ、ヨーロッパ、中東、アフリカの5つの主要地域にさらに分割されています。
北米の市場は、2031 年末までに最大の市場シェアを保持すると予測されています。幹細胞形質転換のプロセスを支援する幹細胞ドナーの増加は、北米での成長を促進することです。米国では、ドナー レジストリのリストに 9百万人を超える潜在的なドナーが登録されています。北米の市場は、予測期間中に 13.53% の CAGR で成長する予定です。2031 年末までに 686.3百万米ドルの最高収益を達成すると予想されています。また、プロテインパウダーの使用量増加による成長も見込めます。米国の人口の約 30% で、プロテイン パウダーの消費量が増加しています。
さらに、市場は地域ごとに次のようにさらに細分化されています。
• 北米(米国およびカナダ);ヨーロッパ(イギリス、ドイツ、フランス、イタリア、スペイン、ハンガリー、ベルギー、オランダ、ルクセンブルク、NORDIC、ポーランド、トルコ、ロシア、その他のヨーロッパ諸国)
• アジア太平洋(中国、インド、日本、韓国、インドネシア、マレーシア、オーストラリア、ニュージーランド、その他のアジア太平洋)
• ラテンアメリカ(ブラジル、メキシコ、アルゼンチン、その他のラテンアメリカ)
• 中東およびアフリカ(イスラエル、GCC [サウジアラビア、UAE、バーレーン、クウェート、カタール、オマーン]、北アフリカ、南アフリカ、中東およびアフリカのその他の地域)。
このレポートでは、ポーターの5つの力の分析、BPSポイント分析などの分析ツールを使用して、さらに詳細な情報に焦点を当てています。市場の分析データは量と値の両方で分類されているため、クライアントが分析の決定を行うためのより詳細な分析を提供します。
[調査レポートの詳細内容について] https://www.kennethresearch.com/report-details/cell-culture-protein-surface-coating-market/10352420
Kenneth Research会社概要
Kenneth Researchは、マルチクライアントの市場調査レポートのディストリビューターで、ビジネスプロフェッショナルが将来の拡張に向けたビジネスプランの戦略を立てるのを支援します。シンジケートされた市場調査レポートの大規模なデータベースの存在とレポートのカスタマイズの範囲の助けを借りて、プラットフォームは、業界の専門家が最終目標を達成するための幅広い機会を提供します。Kenneth Researchは、消費財や食品、ヘルスケア、情報通信技術、エネルギーと電力、化学など、さまざまなレベルの業界にサービスを提供しています。
Contact info
[ 本件に関するお問い合わせ下記まで ]
株式会社: Kenneth Research
電話: +1 313 462 0609
Eメールsales@kennethresearch.com


